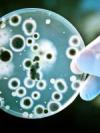

Женское здоровье
Трихомоноз – очень распространенное венерическое заболевание, передающееся половым путем. Оно имеет крайне серьезные последствия при отсутствии правильного лечения. Об основных симптомах развития, а также о том, как проводится лечение этой болезни, поговорим далее.
Для некоторых молодых девушек, которые только начинают свое знакомство с сексуальной жизнью, вопрос о расположении клитора может быть не совсем понятным. Что же из себя представляет этот загадочный орган, как его найти, а также о его предназначении, поговорим далее.
С давних времен для лечения половой сферы применялись различные лекарственные травы. На сегодняшний день многие девушки утверждают, что применение сбора «Маточное гнездо» помогло им излечиться от многих заболеваний. Далее рассмотрим, в каких случаях можно принимать это средство.
На сегодняшний день врачи рекомендуют вступать в первый половой акт только тогда, когда девушка абсолютно к этому готова с моральной и физической точки зрения. О том, что собой представляет девственная плева и какие проблемы могут возникнуть после дефлорации, поговорим далее.
Сифилис – крайне опасное венерическое инфекционное заболевание, которое весьма успешно лечится при своевременном обращении к врачу. Далее расскажем о симптомах проявления болезни, о том, какие бывают стадии развития этого недуга, а также о его последствиях.
Многих женщин, желающих забеременеть, и тех, кто наоборот стремится этого избежать, интересует вопрос о том, как происходит овуляция, сколько дней длится, и какие особенности протекания имеет этот важный процесс. Поговорим об этом подробно далее в нашей статье.
Климакс – естественный и неизбежный процесс увядания детородной функции. И если раньше о менопаузе было не принято говорить вслух, то сейчас, получить подробную информацию, что это такое и как пережить столь сложный период, может абсолютно любая женщина.
Современные методы лечения мастопатии позволяют достаточно эффективно избавиться от всех признаков этой болезни, но прежде, чем начать применять препараты, многие представительницы прекрасного пола предпочитают попробовать народные средства.
Гонорея – это одно из наиболее распространенных венерических заболеваний, передающееся половым путем. Часто инфицированный человек даже не догадывается о своей проблеме, поскольку не испытывает никаких неприятных ощущений в течение долгого времени.
Гиперпластический процесс эндометрия представляет собой доброкачественные разрастания на слизистой оболочке матки, которые могут перерождаться в злокачественные. Давайте рассмотрим особенности этого заболевания подробнее в нашей статье.
Женское здоровье